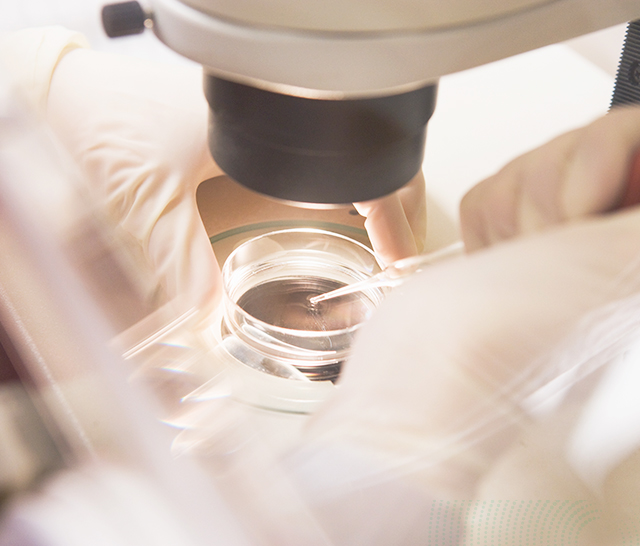

ABOUT US
-

NATURE
By keeping the basics,
we bring nature to you. -

PROMISE
Through continuous research,
we promise you an incredible skin change experience. -

HARMONY
By combining the best natural materials,
we bring you the best products.